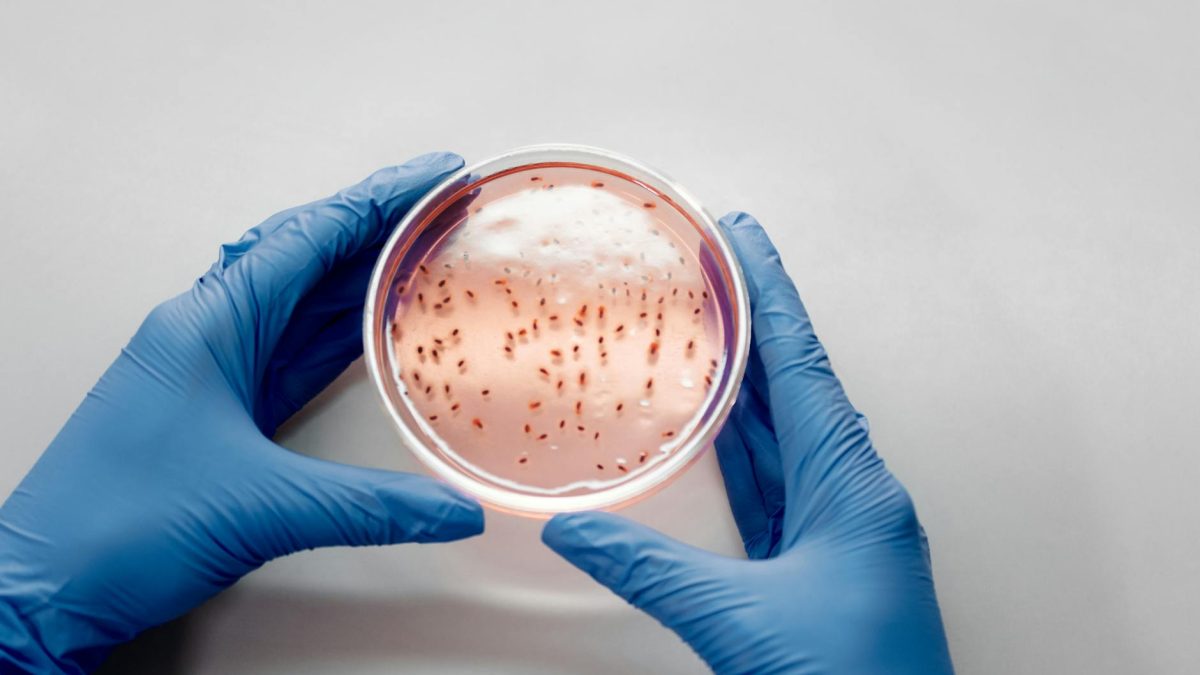
Edward Jenner via Pexels

For years, I approached nutrition the way most people do – following the latest diet trends, counting calories, and hoping for the best. Despite my efforts, I struggled with persistent bloating, irregular digestion, and unexplained fatigue that left me frustrated and searching for answers. Everything changed when I decided to take a gut microbiome test, a decision that would fundamentally alter how I think about food and my body.
The test results arrived two weeks after I mailed in my sample, and what I discovered was both shocking and illuminating. My gut was home to trillions of bacteria, but the balance was significantly off. According to recent research from the American Gut Project, which has analyzed over 15,000 samples, the diversity of gut bacteria varies dramatically between individuals, and mine was notably lacking in several key bacterial families.
Understanding My Microbial Blueprint
The comprehensive report revealed that my Firmicutes to Bacteroidetes ratio was skewed, a common marker associated with metabolic issues. Studies published in Nature Medicine indicate that this ratio can influence everything from weight management to inflammation levels. My test showed I had only 112 distinct bacterial species, while a healthy gut typically harbors 300 to 500 different species.
What struck me most was the personalized nature of the findings. The report identified specific bacterial strains I was deficient in, including Akkermansia muciniphila, which research from the Proceedings of the National Academy of Sciences links to improved metabolic health and gut barrier function. I also had elevated levels of bacteria associated with inflammation, which explained some of my chronic symptoms.
The test also measured my gut’s ability to produce short-chain fatty acids (SCFAs), particularly butyrate. These compounds are crucial for colon health and immune function. My butyrate-producing bacteria were significantly depleted, operating at approximately 40% of optimal levels according to the reference ranges provided.
Abandoning One-Size-Fits-All Diets
Armed with this data, I immediately abandoned the generic dietary advice I had been following. The low-carb diet I had struggled with for months suddenly made sense – my gut lacked the bacteria needed to efficiently process certain complex carbohydrates. Research from Cell magazine has shown that individual glycemic responses to identical foods can vary by as much as 300% based on gut microbiome composition.
I began working with a registered dietitian who specialized in microbiome-based nutrition. Together, we developed a personalized eating plan designed to rebuild my bacterial diversity. This meant incorporating specific prebiotic foods that would feed my beneficial bacteria, including Jerusalem artichokes, leeks, and resistant starches from cooled potatoes and rice.
“The future of nutrition is precision-based, not population-based. When we understand someone’s unique microbial composition, we can make dietary recommendations that actually work for their body, not against it,” explains Dr. Sarah Mitchell, a gastroenterologist and microbiome researcher at Stanford University.
The changes I implemented were surprisingly specific. My test revealed I had genes for lactose metabolism but lacked sufficient Bifidobacterium species to fully benefit from dairy. This explained why yogurt often left me feeling uncomfortable despite being “healthy.” I switched to fermented dairy products specifically rich in Bifidobacterium strains, and the difference was immediate.
The Fiber Revolution in My Kitchen
Perhaps the most significant change was my relationship with fiber. Before testing, I thought fiber was fiber – a simple nutrient to hit a daily target of 25 to 30 grams. My microbiome test revealed the truth is far more complex. Different bacterial species require different types of fiber to thrive.
I learned that my gut particularly needed more soluble fiber to support my depleted Akkermansia populations. I started incorporating these targeted foods into my daily routine:
- Flaxseeds (2 tablespoons daily) – rich in mucilage-type soluble fiber
- Green bananas and plantains – high in resistant starch type 2
- Chicory root and dandelion greens – concentrated sources of inulin
- Mushrooms (shiitake, maitake) – containing beta-glucans that feed specific beneficial strains
- Seaweed and algae – providing unique polysaccharides my gut was missing
Within three weeks of increasing my daily fiber intake to 45 grams with these specific sources, I noticed substantial improvements. My energy levels stabilized, and the afternoon crashes that had plagued me for years began to disappear. Clinical studies in Gut Microbes journal show that targeted fiber interventions can shift microbiome composition in as little as 14 days.
Timing and Food Combinations That Actually Mattered
The microbiome testing also revealed insights about my digestive enzyme production and bile acid metabolism. This information changed not just what I ate, but when and how I combined foods. My report indicated reduced bile acid diversity, which affects fat digestion and the absorption of fat-soluble vitamins.
I began eating my largest, most complex meals earlier in the day when my digestive capacity was strongest. Research from Cell Metabolism demonstrates that our gut bacteria follow circadian rhythms, with different species being more active at different times. By 7 PM, I switched to lighter, easily digestible foods that required less microbial processing.
I also discovered that my gut responded poorly to eating raw vegetables with protein-heavy meals. The test revealed I had lower levels of bacteria that produce cellulase-like enzymes. By lightly cooking vegetables and eating them separately from dense proteins, I dramatically reduced the bloating I had attributed to an unknown food intolerance.
Measuring Progress and Adjusting Course
Three months after implementing my personalized nutrition plan, I retook the microbiome test. The results were remarkable. My bacterial diversity had increased to 187 species, a 67% improvement. My Akkermansia levels had risen from barely detectable to 2.3% of my total microbiome, approaching the healthy range of 3 to 5%.
More importantly, my symptoms had largely resolved. The chronic bloating that once occurred 4 to 5 times per week now happened rarely, maybe twice per month. My energy levels were consistent throughout the day, and I had lost 12 pounds without deliberately restricting calories. Blood work showed improvements in inflammatory markers, with my C-reactive protein dropping from 3.2 mg/L to 0.8 mg/L.
The second test also revealed areas still needing attention. My butyrate producers had improved but remained below optimal levels. This led to another dietary adjustment – adding more resistant starch through properly prepared legumes and focusing on foods rich in polyphenols like berries, green tea, and dark chocolate, which feed butyrate-producing bacteria.
Perhaps most valuable was understanding that my microbiome would continue to evolve. Unlike genetic testing, which provides static information, microbiome testing offers a dynamic snapshot that changes with lifestyle modifications. This meant I could continue to refine my approach based on measurable outcomes rather than guesswork.
The financial investment was significant – approximately 300 dollars for each test – but the return in terms of health improvements and reduced spending on supplements and foods that didn’t work for my body made it worthwhile. More importantly, I gained something priceless: a scientific understanding of my body’s unique needs rather than relying on trial and error.
Looking back, the most profound shift was moving from a restrictive mindset to an additive one. Instead of constantly eliminating foods and following restriction-based diets, I focused on adding diversity and feeding my beneficial bacteria. This approach felt sustainable in a way that previous diets never had.
My experience with gut microbiome testing transformed nutrition from a source of confusion and frustration into a science-based practice tailored to my body’s specific needs. While the field is still evolving and not every finding translates into clear dietary action, the personalized insights provided a foundation for making informed decisions about my health. For anyone struggling with unexplained digestive issues, persistent fatigue, or simply wanting to optimize their nutrition beyond generic recommendations, exploring your gut microbiome might provide the missing piece of the puzzle.
References
Nature Medicine
Cell Metabolism
Proceedings of the National Academy of Sciences
Gut Microbes